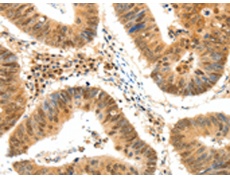
一抗

|
Background: |
This gene encodes a telomere specific protein, TERF2, which is a component of the telomere nucleoprotein complex. This protein is present at telomeres in metaphase of the cell cycle, is a second negative regulator of telomere length and plays a key role in the protective activity of telomeres. While having similar telomere binding activity and domain organization, TERF2 differs from TERF1 in that its N terminus is basic rather than acidic. |
|
Applications: |
ELISA, IHC |
|
Name of antibody: |
TERF2 |
|
Immunogen: |
Synthetic peptide of human TERF2 |
|
Full name: |
telomeric repeat binding factor 2 |
|
Synonyms: |
TRF2; TRBF2 |
|
SwissProt: |
Q15554 |
|
ELISA Recommended dilution: |
2000-5000 |
|
IHC positive control: |
Human colon cancer |
|
IHC Recommend dilution: |
50-200 |

 購物車
購物車 幫助
幫助
 021-54845833/15800441009
021-54845833/15800441009